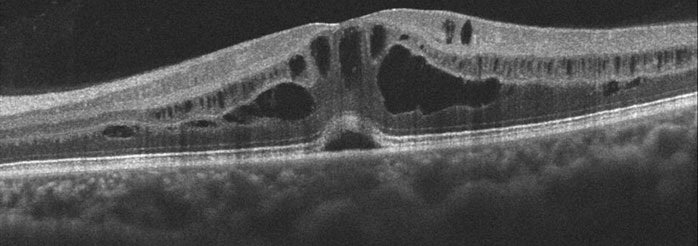

Cystoid macular edema (CME) is a swelling of the central macula, the portion of the retina responsible for our straight-ahead vision. It causes painless central vision blurriness or distortion. There are numerous causes, including eye inflammation (iritis, uveitis and pars planitis), diabetes, hypertensive retinopathy, retinal vein occlusion, and following cataract surgery.

The treatment for CME varies depending on the underlying cause. Treating the intraocular inflammation in uveitis will usually help the CME.
CME following cataract surgery is extremely common and is often asymptomatic, resolving on its own within weeks to months. For patients with symptomatic CME, anti-inflammatory drops or injections are usually successful. Treatment may have to be given for several months. Patients usually recover good vision once the CME resolves.